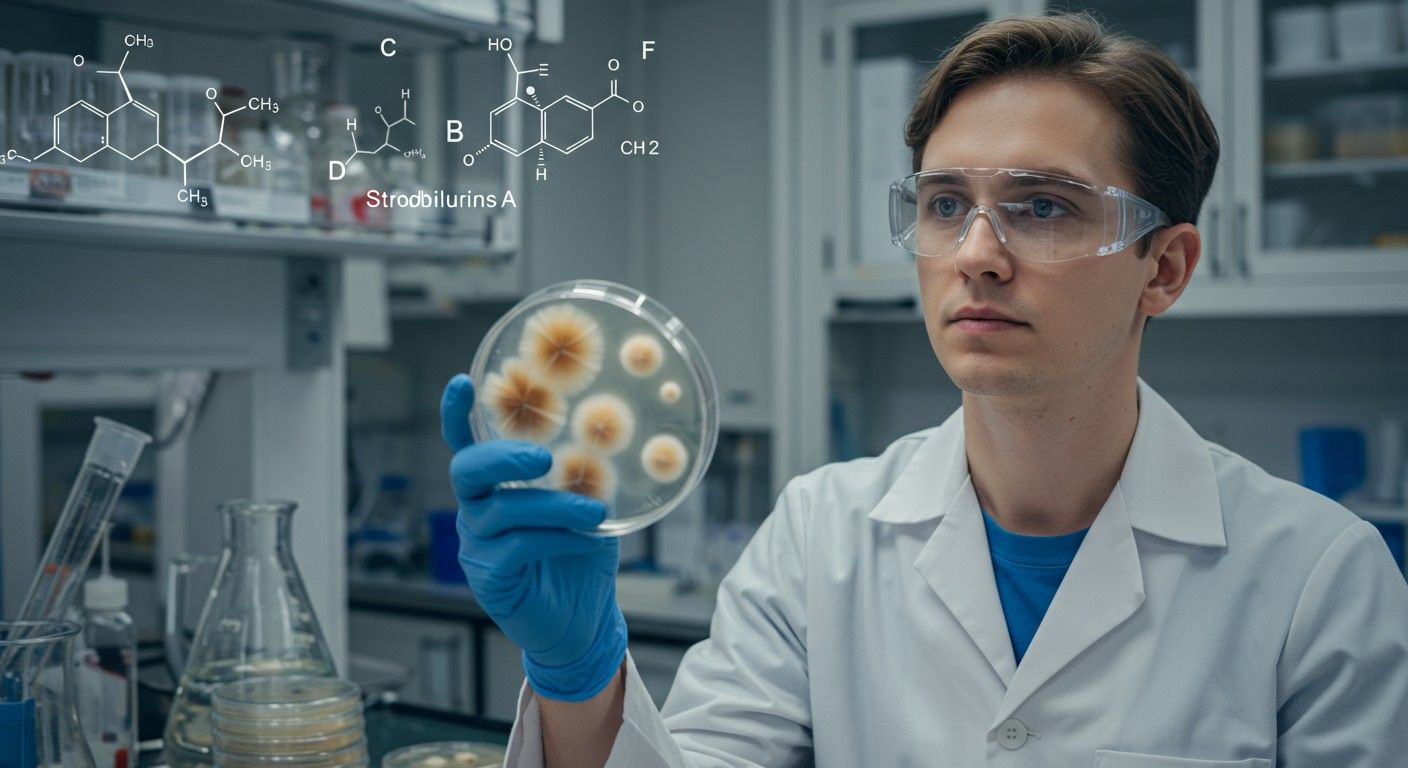
A rezisztencia kezeléséhez integrált védekezési módszerek szükségesek.

A modern mezőgazdaság egyik sarokkövét képezik azok a vegyületek, amelyek képesek megvédeni a növényeket a kórokozó gombák pusztító hatásától. Ezen hatóanyagok között kiemelt helyet foglalnak el a strobilurinok, amelyek forradalmasították a növényvédelmet az elmúlt évtizedekben. Ezek a vegyületek nem csupán hatékonyan lépnek fel a gombás fertőzésekkel szemben, hanem egyedi hatásmechanizmusuk révén hozzájárulnak a növények egészségesebb fejlődéséhez és a termésmennyiség növeléséhez is. A strobilurinok története a természetben gyökerezik, felfedezésük pedig rávilágított a mikrobiális világban rejlő hatalmas kémiai potenciálra.
A strobilurinok eredetileg bizonyos gombafajokból izolált természetes anyagok, amelyek a környezetükben élő más gombák elleni védekezésül termelődnek. A kutatók figyelmét a Strobilurus tenacellus és az Oudemansiella mucida nevű gombák hívták fel, amelyekből az első strobilurin vegyületeket, köztük a strobilurin A-t és az oudemansin A-t (későbbi nevén strobilurin E) izolálták. Ezek a természetes vegyületek képezték az alapját egy teljesen új fungicid osztály kifejlesztésének, amely ma már széles körben alkalmazott a globális mezőgazdaságban. A természetes strobilurinok, mint például az A, B, C, D és E változatok, kémiai szerkezetükben és biológiai aktivitásukban is hasonlóságokat és különbségeket mutatnak, amelyek alapos megértése kulcsfontosságú a modern növényvédelmi stratégiák kidolgozásában.
A strobilurinok eredete és felfedezésének története
A strobilurinok felfedezése a 20. század második felére tehető, amikor a tudósok intenzívebben kezdték vizsgálni a gombák által termelt másodlagos metabolitokat. A cél az volt, hogy új antibiotikumokat és növényvédő szereket találjanak. Az első áttörést a Basidiomycota törzsbe tartozó gombák jelentették, amelyekről kiderült, hogy olyan vegyületeket termelnek, melyek gátolják más gombák növekedését. Ez a jelenség a természetben is megfigyelhető, ahol a gombák kémiai „fegyvereket” használnak a versenytársak távol tartására.
Az első strobilurin, a strobilurin A, a Strobilurus tenacellus nevű, fán élő gombából került izolálásra az 1970-es években a Baseli Egyetemen. A kutatók hamar felismerték a vegyület erős gombaellenes hatását. Ezt követően számos hasonló szerkezetű vegyületet fedeztek fel más gombafajokból, például az Oudemansiella mucida-ból az oudemansin A-t (ami később strobilurin E néven vált ismertté) és a Mycena fajokból. Ezek a természetes vegyületek azonban nem voltak ideálisak mezőgazdasági felhasználásra, főként a fényre való érzékenységük és a viszonylag gyors lebomlásuk miatt. Ez a felismerés indította el a szintetikus analógok fejlesztését, amelyek stabilabbak és hatékonyabbak voltak.
„A természetes strobilurinok felfedezése egy kaput nyitott meg a kémia és a biológia határán, bemutatva, hogy a gombák milyen kifinomult molekuláris stratégiákat alkalmaznak a túlélésért. Ez az ihlet adta a modern, szintetikus fungicid fejlesztések alapját.”
A QoI fungicid osztály (Quinone outside Inhibitors) elnevezés is ebből a kutatásból ered, utalva a strobilurinok egyedi hatásmechanizmusára, amely a mitokondriális légzési lánc külső kinon kötőhelyén (Qo) fejti ki hatását. Az 1980-as és 1990-es években a vegyipari vállalatok, mint például az ICI (ma Syngenta) és a BASF, intenzív kutatásokba kezdtek a természetes strobilurinok szerkezetének módosítására, hogy stabilabb, szélesebb spektrumú és gazdaságosan előállítható szintetikus vegyületeket hozzanak létre. Ennek eredményeként jelentek meg a piacon az első szintetikus strobilurinok, mint az azoxistrobin és a krezoxim-metil, amelyek máig a legfontosabb fungicid hatóanyagok közé tartoznak.
A strobilurinok kémiai szerkezete és osztályozása
A strobilurinok kémiai szerkezete jellegzetes és közös vonásokat mutat, amelyek alapvetően meghatározzák biológiai aktivitásukat. Ezek a vegyületek a metoxi-akrilát vagy metoxi-imino-karbamát szerkezetű molekulák közé tartoznak. Ez a kritikus funkcionális csoport felelős a gombák mitokondriális légzési láncának gátlásáért. Az alapvető kémiai váz egy β-metoxi-akrilát vagy β-metoxi-imino csoportot tartalmaz, amely egy fenilgyűrűhöz vagy más aromás rendszerhez kapcsolódik, gyakran egy további éterkötésen keresztül.
A természetes strobilurinok, mint a strobilurin A, B, C, D, E, közötti különbségek elsősorban a molekula azon részében rejlenek, amely a metoxi-akrilát csoporton kívül esik. Ezek a részek befolyásolják a vegyületek fizikai-kémiai tulajdonságait, például a vízoldhatóságot, a stabilitást és a gombák sejtjeibe való bejutás képességét. A szintetikus strobilurinok fejlesztése során a kutatók ezeket a „testre szabható” részeket használták fel a hatékonyság, a spektrum és a környezeti stabilitás optimalizálására.
A strobilurin A, mint az első felfedezett tag, egy egyszerűbb szerkezetet képvisel, amely egy fenil-propén és egy metoxi-akrilát részből áll. A további természetes változatok, mint a B, C, D és E, apróbb strukturális módosításokat tartalmaznak, például különböző oldalláncokat vagy telítetlenségi fokokat, amelyek befolyásolják biológiai aktivitásukat és stabilitásukat. Ezek a különbségek, bár első pillantásra minimálisnak tűnhetnek, jelentős hatással vannak a vegyületek gombaellenes spektrumára és a lebomlási sebességükre.
A QoI fungicid osztály, melybe a strobilurinok tartoznak, rendkívül sokszínű. Számos különböző kémiai családot foglal magába, amelyek mind ugyanazt a hatásmechanizmust alkalmazzák. A strobilurinok mellett ide tartoznak az oximinoacetátok (pl. krezoxim-metil), az oximinoacetamidok (pl. fenamidon), a metoxi-karbamátok (pl. piraklostrobin), és a dioxolán-metil-akrilátok (pl. fluoxastrobin). Ezek a vegyületek mind tartalmazzák azt a kulcsfontosságú „farmakofór” részt, amely a mitokondriális légzési lánc gátlásához szükséges, de a molekula többi része eltérő, lehetővé téve a különböző gyártók számára, hogy saját, szabadalmaztatott vegyületeket fejlesszenek ki.
Hatásmechanizmus: a mitokondriális légzés gátlása
A strobilurinok hatásmechanizmusa egyedülálló és rendkívül specifikus, ami hozzájárul kiemelkedő hatékonyságukhoz. Ezek a vegyületek a gombák mitokondriális légzési láncát célozzák meg, pontosabban a citokróm bc1 komplexet (más néven komplex III). A mitokondriális légzés alapvető folyamat minden eukarióta sejtben, beleértve a gombákat is, mivel ez termeli a sejt energiaellátásáért felelős ATP-t.
A strobilurinok a citokróm bc1 komplex külső, kinon kötőhelyén (ezt nevezik Qo helynek vagy Q-outside helynek) fejtik ki hatásukat. Ezen a helyen megakadályozzák az ubikinon redukcióját, ami megszakítja az elektronátvitelt a komplexben. Ennek következtében a protongrádiens, amely az ATP szintéziséhez szükséges, nem tud kialakulni a mitokondriális membránon keresztül. Végeredményben a gombasejtek energiaellátása leáll, ami gátolja a spórák csírázását, a micélium növekedését és a sporulációt. Ez a folyamat a gombák számára létfontosságú, így a blokkolása gyorsan elpusztítja őket vagy megakadályozza szaporodásukat.
A strobilurinok hatása viszonylag gyorsan megfigyelhető, és a gombafejlődés több szakaszában is kifejti hatását, de leginkább a preventív, azaz megelőző alkalmazás során a leghatékonyabb. Ha a fertőzés még nem történt meg, de a kórokozó spórái jelen vannak, a strobilurinok megakadályozzák a csírázást és a behatolást a növényi szövetekbe. Bizonyos mértékig rendelkeznek kuratív (gyógyító) hatással is, azaz a már kialakult fertőzés korai szakaszában is képesek megállítani a betegség terjedését, de ez a képesség általában gyengébb, mint a preventív hatás.
A specifikus célpont, a Qo hely, teszi a strobilurinokat rendkívül hatékonnyá, de egyben sebezhetővé is a rezisztencia kialakulásával szemben. Mivel a gombák mitokondriális légzése alapvető folyamat, a Qo helyen bekövetkező apró genetikai változások, például egy pontmutáció, elegendőek lehetnek ahhoz, hogy a strobilurinok ne tudjanak megfelelően kötődni, és így elveszítsék hatékonyságukat. Ezt a jelenséget részletesebben tárgyaljuk majd a rezisztencia fejezetben.
„A strobilurinok a gombák energiaellátásának központjába csapnak le. A mitokondriális légzési lánc blokkolásával gyakorlatilag kiéheztetik a kórokozót, megakadályozva annak növekedését és terjedését.”
Strobilurin A: az első és az alapvető vegyület

A strobilurin A nem csupán az elsőként felfedezett strobilurin vegyület, hanem az egész osztály névadója is. Ezt a molekulát a Strobilurus tenacellus nevű gombából izolálták, és szerkezete szolgált alapul a későbbi szintetikus analógok tervezéséhez és fejlesztéséhez. Kémiai szempontból a strobilurin A egy viszonylag egyszerű molekula, amely egy β-metoxi-akrilát csoportot tartalmaz, mely egy fenil-propén egységhez kapcsolódik. Ez a szerkezet adja meg a vegyület alapvető fungicid aktivitását.
A strobilurin A felfedezésekor a kutatók rendkívül ígéretesnek találták gombaellenes hatását. Széles spektrumú aktivitást mutatott számos mezőgazdasági kórokozóval szemben. Azonban a természetes eredetű strobilurin A-nak komoly korlátai voltak, amelyek gátolták a közvetlen mezőgazdasági alkalmazását. A legjelentősebb probléma a fényérzékenysége volt. Ultraibolya (UV) fény hatására gyorsan lebomlott, ami jelentősen csökkentette a hatóanyag perzisztenciáját és hatékonyságát a szabadföldi körülmények között. Emellett a stabilitása a talajban és a növényi felületeken is korlátozott volt, ami gyakori újraalkalmazást tett volna szükségessé, ami gazdaságilag nem volt fenntartható.
Ezek a korlátok motiválták a vegyészeket arra, hogy olyan szintetikus analógokat hozzanak létre, amelyek megtartják a strobilurin A kiváló fungicid hatását, de javított fizikai-kémiai tulajdonságokkal rendelkeznek. A cél az volt, hogy stabilabb, tartósabb és hatékonyabban szállítható molekulákat hozzanak létre a növényekbe. A szerkezeti módosítások során a kutatók a metoxi-akrilát csoportot érintetlenül hagyták, mint a hatásmechanizmus kulcsfontosságú részét, de a molekula többi részét (a fenil-propén oldalláncot) variálták. Ez a stratégia vezetett el a ma is használt szintetikus strobilurinokhoz, mint például az azoxistrobinhoz, a krezoxim-metilhez és a piraklostrobinhoz, amelyek mind a strobilurin A szerkezetének és hatásmechanizmusának elvén alapulnak, de lényegesen stabilabbak és felhasználóbarátabbak.
A strobilurin A tehát nem önmagában vált széles körben alkalmazott fungiciddé, hanem inkább egy prototípusként szolgált, amely megnyitotta az utat egy teljesen új és rendkívül sikeres fungicid osztály kifejlesztése előtt. Felfedezése alapvető fontosságú volt a növényvédelem történetében, és rávilágított arra, hogy a természetes termékek hogyan inspirálhatják a modern kémiai innovációt.
Strobilurin B, C, D, E: a fejlődés és a változatok
A strobilurin A felfedezését követően a kutatók további hasonló szerkezetű vegyületeket izoláltak különböző gombafajokból. Ezeket a vegyületeket sorban strobilurin B, C, D és E néven azonosították, jelezve kémiai rokonságukat, de egyedi szerkezeti jellemzőiket is. Ezek a természetes változatok mind a mitokondriális légzés gátlásán keresztül fejtik ki hatásukat, de eltérő hatékonysággal és stabilitással rendelkezhetnek.
Strobilurin B
A strobilurin B szerkezetileg nagyon hasonlít a strobilurin A-hoz, de a fenil-propén oldalláncban egy kis módosítást tartalmaz. Ez a módosítás befolyásolhatja a vegyület fizikai-kémiai tulajdonságait és biológiai aktivitását, de alapvető hatásmechanizmusa megegyezik az A-val. Ezt a vegyületet szintén a Strobilurus tenacellus gombából izolálták, és a kutatások során segített megérteni, hogy milyen szerkezeti elemek kritikusak a fungicid aktivitáshoz, és melyek módosíthatók a tulajdonságok finomhangolása érdekében.
Strobilurin C
A strobilurin C egy másik természetes eredetű strobilurin, amely szerkezetében eltér az A és B változatoktól. Ezek az eltérések gyakran olyan funkcionális csoportok jelenlétét jelentik, amelyek befolyásolják a molekula polaritását, méretét és a gombasejtekbe való bejutásának képességét. A C változat tanulmányozása hozzájárult a strobilurinok szerkezet-aktivitás összefüggéseinek (SAR) mélyebb megértéséhez, ami kulcsfontosságú volt a szintetikus fejlesztések során.
Strobilurin D
A strobilurin D is a természetes strobilurin család tagja, melynek szerkezetét és biológiai hatásait szintén vizsgálták. Bár az A változathoz képest kevésbé ismert vagy széles körben tanulmányozott, a D változat is hozzájárult a strobilurinok sokféleségének és potenciális alkalmazási lehetőségeinek feltárásához. Az ilyen vegyületek izolálása és karakterizálása rávilágított arra, hogy a természet milyen gazdag forrása lehet új hatóanyagoknak.
Strobilurin E (Oudemansin A)
A strobilurin E, más néven oudemansin A, az Oudemansiella mucida gombából izolált vegyület. Ez a molekula szerkezetileg ismét eltér a Strobilurus fajokból származó strobilurinoktól, de ugyanazt a hatásmechanizmust alkalmazza. Az oudemansin A felfedezése megerősítette azt a tényt, hogy a mitokondriális légzést gátló metoxi-akrilát típusú vegyületek széles körben elterjedtek a gombákban, és különböző kémiai környezetben is kialakulhatnak. Az oudemansin A is viszonylag instabil volt fény hatására, ami szintén a szintetikus analógok fejlesztése felé terelte a kutatásokat.
Az alábbi táblázat összefoglalja a természetes strobilurinok főbb jellemzőit:
| Vegyület | Természetes forrás | Főbb szerkezeti jellemzők | Megjegyzések |
|---|---|---|---|
| Strobilurin A | Strobilurus tenacellus | Fenil-propén váz, metoxi-akrilát csoport | Az első felfedezett, névadó vegyület. Fényérzékeny. |
| Strobilurin B | Strobilurus tenacellus | Hasonló az A-hoz, kisebb strukturális eltérések | Az A változathoz hasonló hatásmechanizmus. |
| Strobilurin C | Strobilurus tenacellus | Egyedi oldalláncok a fenil-propén vázon | Hozzájárult a szerkezet-aktivitás összefüggések megértéséhez. |
| Strobilurin D | Strobilurus tenacellus | Specifikus kémiai módosítások | Kevésbé ismert, de a család tagja. |
| Strobilurin E (Oudemansin A) | Oudemansiella mucida | Fenil-oxazol-metil-akrilát váz | Más gombafajból izolált, eltérő, de hasonló alapvázzal. Fényérzékeny. |
Ezeknek a természetes vegyületeknek a tanulmányozása alapvető fontosságú volt a strobilurinok kémiai és biológiai profiljának megértésében. Bár önmagukban nem váltak széles körben használt fungicid hatóanyagokká instabilitásuk miatt, az általuk képviselt kémiai struktúrák és hatásmechanizmusok inspirálták a modern, stabil és hatékony szintetikus strobilurinok kifejlesztését, amelyek ma már a növényvédelem elengedhetetlen eszközei.
Szintetikus strobilurinok: a mezőgazdasági forradalom
A természetes strobilurinok, mint a strobilurin A vagy az oudemansin A, ígéretes fungicid aktivitással rendelkeztek, azonban a fényérzékenységük és a környezeti instabilitásuk miatt nem voltak alkalmasak a mezőgazdasági felhasználásra. Ez a felismerés ösztönözte a vegyipari vállalatokat, hogy olyan szintetikus analógokat fejlesszenek ki, amelyek megtartják a természetes vegyületek kiváló gombaellenes hatását, de lényegesen stabilabbak és gazdaságosabban előállíthatók. Ez a kutatás-fejlesztési folyamat egy valóságos forradalmat hozott a növényvédelemben.
Az 1990-es évek elején jelentek meg az első kereskedelmi forgalomba hozott szintetikus strobilurinok, amelyek gyorsan a legfontosabb fungicid osztályok közé emelkedtek. Ezek a vegyületek a metoxi-akrilát vagy metoxi-imino szerkezeti elemet tartalmazzák, amely a Qo hely gátlásáért felelős. A molekula többi részét azonban úgy alakították ki, hogy az javítsa a stabilitást, a rendszerszintű mozgást a növényben (szisztemikus hatás), és a gombaellenes spektrumot.
A legfontosabb szintetikus strobilurinok közé tartozik:
- Azoxistrobin (Syngenta): Az egyik legelső és legszélesebb körben használt strobilurin. Széles spektrumú, szisztemikus és transzlamináris mozgású, ami azt jelenti, hogy a növényen belül is képes eljutni a fertőzött részekhez.
- Krezoxim-metil (BASF): Szintén korán bevezetett hatóanyag, kiváló preventív és kuratív hatással. Különösen hatékony a lisztharmat és a peronoszpóra ellen.
- Piraklostrobin (BASF): Magas hatékonyságú, széles spektrumú strobilurin, amelyről ismert, hogy a gombaölő hatáson kívül pozitív élettani hatásai is vannak a növényekre (lásd „green effect”).
- Trifloxistrobin (Syngenta): Jó gőznyomású, ami hozzájárul a hatóanyag jobb eloszlásához a növény felületén, és védi a nehezen elérhető részeket is.
- Fluoxastrobin (Bayer): Kiemelkedő esőállósággal és tartós hatással rendelkezik.
- Dimerkoxistrobin, Metominostrobin, Orysastrobin, Picoxystrobin és sok más.
Ezek a szintetikus vegyületek jelentősen felülmúlták természetes elődeiket stabilitásban és hatékonyságban. Az azoxistrobin például több mint 100 növénykultúrában és több mint 400 gombás betegség ellen engedélyezett világszerte. A szintetikus strobilurinok fejlesztése lehetővé tette a gazdálkodók számára, hogy hatékonyabban védekezzenek a termésveszteséget okozó gombás betegségek ellen, hozzájárulva a magasabb terméshozamokhoz és a jobb minőségű termékekhez.
A „metoxi-akrilát” vagy „metoxi-imino” szerkezeti elem fontossága nem csupán a hatásmechanizmusban rejlik, hanem abban is, hogy ez a csoport viszonylag könnyen szintetizálható és módosítható. Ez a kémiai rugalmasság tette lehetővé a széles körű kutatást és fejlesztést, amelynek eredményeként ma már számos különböző strobilurin hatóanyag áll rendelkezésre a piacon, mindegyik optimalizálva specifikus növénykultúrákhoz és kórokozókhoz.
„A szintetikus strobilurinok a kémiai innováció diadalát jelentik. A természetes molekulák ihlette, de laboratóriumban tökéletesített vegyületek új korszakot nyitottak a növényvédelemben, stabilabbá és termelékenyebbé téve a mezőgazdaságot.”
Alkalmazási területek és előnyök a növényvédelemben
A szintetikus strobilurinok széles körű elterjedésüket kivételes hatékonyságuknak, széles spektrumú aktivitásuknak és kedvező élettani hatásaiknak köszönhetik. Ezek a vegyületek ma már a modern növényvédelem elengedhetetlen eszközei számos mezőgazdasági kultúrában.
Széles spektrumú védelem
A strobilurinok a gombák rendkívül széles skálája ellen hatékonyak. Ide tartoznak az Ascomycota, Basidiomycota és Deuteromycota törzsekbe tartozó kórokozók. Különösen hatékonyak az alábbi betegségek ellen:
- Rozsdabetegségek (pl. gabonarozsda): Puccinia fajok.
- Listharmat (pl. gabonalisztharmat, szőlőlisztharmat): Erysiphe, Blumeria fajok.
- Peronoszpóra (pl. szőlőperonoszpóra): Plasmopara viticola és más Oomycetes.
- Alternária (pl. burgonya alternária): Alternaria fajok.
- Szeptóriás levélfoltosság (pl. búza szeptóriás levélfoltossága): Zymoseptoria tritici.
- Kukorica fuzárium: Fusarium fajok.
- Rizs rizsperonoszpóra: Magnaporthe oryzae.
Ez a széles spektrum lehetővé teszi, hogy egyetlen kezeléssel több betegség ellen is védekezni lehessen, ami egyszerűsíti a növényvédelmi programokat és csökkenti a felhasznált hatóanyagok számát.
Különböző növénykultúrákban való alkalmazás
A strobilurinokat rendkívül sokféle növénykultúrában alkalmazzák, többek között:
- Gabonafélék: búza, árpa, kukorica, rizs.
- Gyümölcsök: alma, körte, szőlő, csonthéjasok (pl. őszibarack, cseresznye).
- Zöldségek: burgonya, paradicsom, uborka, hagyma, paprika.
- Olajos növények: repce, napraforgó.
- Dísznövények és gyep.
Ez a sokoldalúság teszi a strobilurinokat a globális mezőgazdaság egyik legfontosabb fungicid osztályává.
Preventív és kuratív hatás
A strobilurinok elsősorban preventív, azaz megelőző hatásúak. Ez azt jelenti, hogy a leghatékonyabbak, ha a fertőzés megjelenése előtt, vagy annak nagyon korai szakaszában alkalmazzák őket, megakadályozva a spórák csírázását és a növénybe való behatolást. Azonban bizonyos mértékben kuratív (gyógyító) hatással is rendelkeznek, képesek megállítani a már kialakult fertőzés terjedését, különösen, ha még a betegség kezdeti stádiumában történik a kezelés.
Fiziológiai hatások a növényekre (a „green effect”)
A strobilurinok egyik különleges és igen kedvező tulajdonsága, hogy a gombaölő hatáson túl pozitív élettani hatásokat is kiválthatnak a kezelt növényekben. Ezt a jelenséget gyakran „green effect”-nek, azaz „zöld hatásnak” nevezik. Ez a hatás többek között az alábbiakban nyilvánul meg:
- Fokozott fotoszintézis: A strobilurinok késleltethetik a növények öregedését (szeneszcenciáját), hosszabb ideig fenntartva a levelek zöld színét és a fotoszintetikus aktivitást.
- Stressztűrés javulása: A kezelt növények ellenállóbbá válnak a környezeti stresszel szemben, mint például a szárazság, a hőmérsékleti ingadozások vagy a tápanyaghiány.
- Nitrogénfelvétel és -felhasználás optimalizálása: Egyes strobilurinok javíthatják a nitrogén asszimilációját, ami hozzájárul a jobb növekedéshez és a magasabb terméshozamhoz.
- Vízfelhasználás hatékonyságának növelése: A sztómák szabályozásán keresztül csökkenthetik a transzspirációt, javítva a növények vízháztartását.
Ezek a fiziológiai hatások hozzájárulnak a növények általános egészségének javulásához, a stressz okozta termésveszteség csökkenéséhez és végső soron a magasabb és jobb minőségű terméshozamhoz. Ez a kettős hatás – gombaölő és növényfiziológiai – teszi a strobilurinokat különösen vonzóvá a modern mezőgazdaság számára.
Kombinált készítmények szerepe
A rezisztencia kialakulásának megelőzése és a hatásspektrum további bővítése érdekében a strobilurinokat gyakran kombinálják más hatásmechanizmusú fungicid hatóanyagokkal, például triazolokkal vagy karboxamidokkal. Ezek a kombinált készítmények lehetővé teszik a szélesebb körű védekezést és csökkentik a rezisztencia kialakulásának kockázatát, mivel a kórokozónak egyszerre több támadási ponton kell rezisztenciát kialakítania.
Rezisztencia kialakulása és kezelése
A strobilurinok kiváló hatékonysága és széleskörű alkalmazása sajnos magával hozta a rezisztencia kialakulásának kockázatát a célgombákban. Mivel a strobilurinok hatásmechanizmusa rendkívül specifikus, egyetlen molekuláris célpontra hatnak (a mitokondriális citokróm bc1 komplex Qo helyére), a gombákban viszonylag könnyen alakulhat ki rezisztencia egy egyszerű genetikai mutáció révén.
A QoI rezisztencia mechanizmusai
A strobilurinokkal szembeni rezisztencia leggyakoribb mechanizmusa egy pontmutáció a citokróm b génben, amely a citokróm bc1 komplexet kódolja. A legelterjedtebb mutáció a G143A mutáció, ahol a 143-as pozícióban lévő glicin aminosav alaninra cserélődik. Ez a változás megakadályozza a strobilurin molekula megfelelő kötődését a Qo helyhez, miközben a gomba légzési lánca továbbra is működőképes marad. A G143A mutáció rendkívül gyakori és számos mezőgazdasági kórokozóban (pl. Blumeria graminis – gabonalisztharmat, Zymoseptoria tritici – búza szeptóriás levélfoltossága, Plasmopara viticola – szőlőperonoszpóra) kimutatták. Ez a mutáció magas szintű rezisztenciát eredményez.
Egy másik, kevésbé gyakori mutáció az F129L mutáció, ahol a 129-es pozícióban lévő fenilalanin leucinra cserélődik. Ez a mutáció általában alacsonyabb szintű rezisztenciát okoz, mint a G143A, és gyakran olyan gombafajokban fordul elő, amelyek nem hordozzák a G143A mutációt. Más ritkább mutációk is előfordulhatnak, de a G143A a legjelentősebb a mezőgazdasági szempontból.
A rezisztencia kialakulásának gyakorisága és gyorsasága
A rezisztencia kialakulásának kockázatát növeli a strobilurinok széles körű és gyakori, néha kizárólagos alkalmazása. Mivel a strobilurinok kiváló hatékonyságúak és a „green effect” miatt is kedveltek, hajlamosak a gazdálkodók túlzottan támaszkodni rájuk. Ez a szelekciós nyomás felgyorsítja a rezisztens törzsek elszaporodását, mivel a rezisztens egyedek túlélnek és szaporodnak, míg az érzékeny egyedek elpusztulnak.
Stratégiák a rezisztencia megelőzésére
A strobilurinok hosszú távú hatékonyságának megőrzése érdekében elengedhetetlen a rezisztencia menedzsment. A Fungicide Resistance Action Committee (FRAC) nemzetközi szervezet iránymutatásokat ad ki a rezisztencia kockázatának csökkentésére. A kulcsfontosságú stratégiák a következők:
- Rotáció és keverékek: Soha ne alkalmazzunk egymás után kétszer azonos hatásmechanizmusú fungicidet. Váltogassuk a különböző FRAC kódú (azaz eltérő hatásmechanizmusú) hatóanyagokat, vagy használjunk előre gyártott, illetve tankkeverékben összeállított kombinált készítményeket, amelyek több hatásmechanizmusú hatóanyagot tartalmaznak. Ez csökkenti a szelekciós nyomást egyetlen célpontra.
- Korlátozott alkalmazási szám: Korlátozzuk a strobilurinok alkalmazásainak számát egy vegetációs időszakban. A FRAC általában maximum két strobilurin tartalmú kezelést javasol egy szezonban, és soha ne haladjuk meg a teljes fungicid kezelések felét strobilurinnal.
- Preventív alkalmazás: A strobilurinok a leghatékonyabbak preventíven. A már kialakult, erősen fertőzött állományban való alkalmazás növeli a rezisztencia kialakulásának kockázatát, mivel nagyobb a rezisztens mutánsok száma.
- Dózisok betartása: Mindig a címkén feltüntetett, ajánlott dózisokat alkalmazzuk. Az alacsonyabb dózisok nem elegendőek a kórokozó teljes elpusztítására, de elegendő szelekciós nyomást gyakorolnak a rezisztens törzsek kiválasztására.
- Integrált növényvédelem (IPM): Kombináljuk a kémiai növényvédelmet más módszerekkel, például ellenálló fajták termesztésével, vetésforgóval, agrotechnikai módszerekkel (pl. növényi maradványok eltávolítása).
A rezisztencia menedzsment nem csupán a strobilurinok, hanem az összes fungicid hatékonyságának megőrzése szempontjából kritikus. A felelős és tudatos alkalmazás elengedhetetlen a modern mezőgazdaság fenntarthatósága érdekében.
Környezeti hatások és biztonsági szempontok
A strobilurinok széles körű alkalmazása a mezőgazdaságban felveti a környezeti hatások és a biztonsági szempontok kérdését. Mint minden növényvédő szer esetében, itt is alapvető fontosságú a hatóanyagok sorsának, toxikológiai profiljának és maradékanyag-tartalmának alapos vizsgálata.
Talajban és vízben való sorsuk
A strobilurinok talajban való lebomlása általában mérsékelt. A lebomlás sebességét befolyásolja a talaj típusa, a pH, a szervesanyag-tartalom és a mikrobiális aktivitás. Egyes strobilurinok, mint például az azoxistrobin, viszonylag gyorsan lebomlanak a talajban (fél-életideje néhány naptól néhány hétig terjed), míg mások, mint a piraklostrobin, hosszabb ideig is perzisztálhatnak. A lebomlás főként mikrobiális úton történik, de fotolízis (fény hatására történő bomlás) is szerepet játszhat a talajfelszínen.
A vízbe jutás a strobilurinok esetében potenciális aggodalomra adhat okot, különösen a felszíni vizek szennyezése szempontjából. Bár a strobilurinok általában közepesen vagy erősen kötődnek a talajhoz, ami csökkenti a kimosódás kockázatát a talajvízbe, a felszíni vizekbe való bemosódás vagy a permetezési elsodródás révén bejuthatnak. A strobilurinok vízi szervezetekre gyakorolt hatásait ezért kiemelten vizsgálják. Egyes strobilurinok mérgezőek lehetnek a vízi algákra, halakra és gerinctelenekre, ezért az alkalmazás során szigorú óvintézkedések betartása szükséges a vizek védelme érdekében.
Toxikológiai profil
Az engedélyezési eljárások során a strobilurinok emberre és állatokra gyakorolt toxikológiai hatásait alaposan vizsgálják. Általánosságban elmondható, hogy a strobilurinokat alacsony toxicitású vegyületeknek tekintik az emlősök számára, ha a címkén feltüntetett utasításoknak megfelelően alkalmazzák őket. Nincs bizonyíték arra, hogy karcinogén, mutagén vagy reprodukciót károsító hatásuk lenne az emberre nézve a normál expozíciós szinteken.
Azonban, mint minden kémiai anyag esetében, a kezelőkre és a környezetben élő hasznos szervezetekre (pl. méhek, ragadozó rovarok, földigiliszták) való hatás is fontos szempont. A strobilurinok általában csekély kockázatot jelentenek a méhekre, de a hasznos rovarokra és az atkákra gyakorolt hatásuk fajonként és hatóanyagonként eltérő lehet. Az integrált növényvédelem (IPM) keretében a szelektívebb hatóanyagok előnyben részesítése és az alkalmazási időzítés optimalizálása segíthet minimalizálni a nem célszervezetekre gyakorolt hatást.
Maradékanyagok kérdése az élelmiszerekben
Az élelmiszerekben található strobilurin maradékanyagok szigorú szabályozás alá esnek. Minden országban meghatározzák az úgynevezett maximális maradékanyag-határértékeket (MRL – Maximum Residue Limit), amelyek a fogyasztók egészségének védelmét szolgálják. Ezeket az értékeket a vegyületek toxikológiai profilja és a fogyasztási szokások alapján állapítják meg.
A gazdálkodóknak szigorúan be kell tartaniuk a permetezési fordulók számát, a dózisokat és az élelmezés-egészségügyi várakozási időt (a kezelés és a betakarítás közötti minimális időtartam), hogy a betakarított terményekben a maradékanyag-szintek az MRL alatt maradjanak. A rendszeres ellenőrzések és a jogszabályok szigorú betartása biztosítja, hogy a strobilurinokkal kezelt élelmiszerek biztonságosan fogyaszthatók legyenek.
Szabályozási keretek és engedélyezés
A strobilurinok engedélyezése és forgalmazása szigorú szabályozási keretek között történik világszerte. Az Európai Unióban például az Európai Élelmiszerbiztonsági Hatóság (EFSA) végzi a hatóanyagok kockázatértékelését, mielőtt azok engedélyt kaphatnának. Ez a folyamat kiterjed a toxikológiai, ökotoxikológiai és környezeti sorsvizsgálatokra, biztosítva, hogy csak olyan vegyületek kerülhessenek forgalomba, amelyek biztonságosan alkalmazhatók, ha a címkén feltüntetett utasításokat betartják.
„A strobilurinok hatékony eszközök, de felelős alkalmazásuk kulcsfontosságú. A környezeti hatások minimalizálása és a fogyasztói biztonság garantálása megköveteli a tudományos alapú szabályozás és a gazdálkodói gyakorlatok folyamatos összehangolását.”
A strobilurinok jövője és új fejlesztési irányok
A strobilurinok a modern növényvédelem egyik legsikeresebb hatóanyagcsaládját képviselik, és várhatóan a jövőben is fontos szerepet fognak játszani. Azonban a rezisztencia kialakulása és a fenntartható mezőgazdaság iránti növekvő igény folyamatos innovációt tesz szükségessé ezen a területen.
Új generációs QoI-k
A kutatók továbbra is dolgoznak az új generációs strobilurinok és más QoI-k fejlesztésén. A cél olyan molekulák létrehozása, amelyek még hatékonyabbak, szélesebb spektrumúak, jobb környezeti profillal rendelkeznek, és ami a legfontosabb, képesek leküzdeni a meglévő rezisztenciát. Ez utóbbit gyakran úgy próbálják elérni, hogy olyan szerkezeti módosításokat végeznek, amelyek lehetővé teszik a kötődést a mutáns Qo helyhez is, vagy eltérő, de hasonló hatásmechanizmusú vegyületeket fejlesztenek.
Egyes új fejlesztések például a Qil típusú gátlók felé mutatnak, amelyek a citokróm bc1 komplex Qi (Q-inside) helyén hatnak. Bár ezek nem szigorúan strobilurinok, hasonlóan a mitokondriális légzést gátolják, és alternatívát jelenthetnek a QoI rezisztenciával szemben.
Kombinált hatóanyagok és a „pre-mix” stratégiák
A jövőben még nagyobb hangsúlyt kapnak a kombinált készítmények, amelyek két vagy több, eltérő hatásmechanizmusú hatóanyagot tartalmaznak. Ez a stratégia kulcsfontosságú a rezisztencia menedzsmentjében, mivel csökkenti a szelekciós nyomást egyetlen hatóanyagra, és növeli a hatásspektrumot. A „pre-mix” termékek, azaz az előre formulált kombinációk, kényelmesebbé teszik a gazdálkodók számára a megfelelő rezisztencia-ellenes stratégia alkalmazását.
Célzottabb alkalmazási módszerek
A precíziós mezőgazdaság fejlődésével a strobilurinok és más növényvédő szerek célzottabb alkalmazása is várható. Ez magában foglalhatja a drónokkal végzett permetezést, a szenzorok által vezérelt dózisok alkalmazását, vagy a betegség előrejelző modellek felhasználását, amelyek pontosan meghatározzák, mikor és hol van szükség kezelésre. Ez nemcsak a hatékonyságot növeli, hanem csökkenti a felhasznált hatóanyag mennyiségét és a környezeti terhelést is.
A rezisztencia kezelésének innovációi
A rezisztencia kialakulása továbbra is az egyik legnagyobb kihívás. Az innovációk ezen a területen magukban foglalhatják a rezisztencia monitorozásának fejlesztését (gyorsabb és pontosabb detektálási módszerek), valamint olyan új technológiák bevezetését, amelyek segítenek a gazdálkodóknak a megfelelő rezisztencia-ellenes stratégiák kiválasztásában. A digitális eszközök és az adatvezérelt döntéshozatal egyre fontosabbá válik a rezisztencia menedzsmentben.
A fenntartható mezőgazdaságban betöltött szerepük
A strobilurinok, mint a modern növényvédelem részei, hozzájárulnak a fenntartható mezőgazdasághoz azáltal, hogy biztosítják a termésbiztonságot és a magas minőségű élelmiszertermelést. A „green effect” révén a növények stressztűrő képességének javítása és a terméshozam növelése kulcsfontosságú a növekvő globális népesség élelmezésében. Azonban a fenntarthatóság szempontjából elengedhetetlen a felelős és integrált alkalmazásuk, figyelembe véve a környezeti és egészségügyi hatásokat is. A jövő feladata a strobilurinok hatékonyságának megőrzése, miközben minimalizálják a lehetséges negatív következményeket, és integrálják őket egy holisztikus növényvédelmi rendszerbe.
